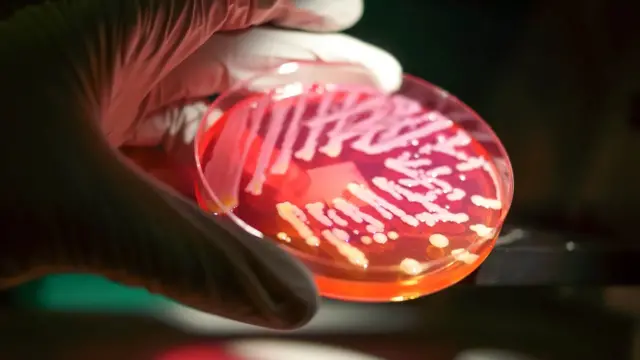
Expérience en laboratoire.

Comment les bactéries intestinales contrôlent votre cerveau

Crédit photo, Getty Images
- Author, Miriam Frankel et Matt Warren
- Role, BBC Future
S'occuper des multitudes de bactéries, champignons et autres micro-organismes qui vivent dans nos intestins pourrait nous aider à mieux penser et même offrir de nouveaux moyens de traiter les troubles mentaux.
Votre intestin est une colonie extraterrestre animée et prospère. Ils sont des trillions et comprennent des milliers d'espèces différentes. Nombre de ces micro-organismes, dont les bactéries, les archées et les eucaryas, étaient là bien avant l'homme, ont évolué à nos côtés et sont aujourd'hui beaucoup plus nombreux que nos propres cellules.
En effet, comme l'a dit John Cryan, professeur d'anatomie et de neurosciences à l'University College Cork, de manière assez frappante dans une conférence TEDx : "Lorsque vous allez aux toilettes et que vous vous débarrassez de certains de ces microbes, pensez simplement que vous devenez plus humain."
Collectivement, ces légions microbiennes sont connues sous le nom de "microbiote" - et elles jouent un rôle bien établi dans le maintien de notre santé physique, de la digestion et du métabolisme à l'immunité. Elles produisent également des composés vitaux que le corps humain est incapable de fabriquer lui-même.
Mais si elles avaient aussi une ligne directe avec notre esprit ? Dans notre nouveau livre, Are You Thinking Clearly ? 29 Reasons You Aren't And What To Do About It, nous explorons les dizaines de facteurs internes et externes qui affectent et manipulent notre façon de penser, de la génétique, la personnalité et les préjugés à la technologie, la publicité et le langage. Et il s'avère que les microbes qui vivent dans notre corps peuvent avoir un contrôle surprenant sur notre cerveau.
Au cours des dernières décennies, les chercheurs ont commencé à découvrir des preuves curieuses, convaincantes - et parfois controversées - suggérant que le microbiote intestinal ne contribue pas seulement à maintenir notre cerveau en parfait état de marche en l'aidant à libérer des nutriments à partir de notre alimentation, mais qu'il peut également contribuer à façonner nos pensées et notre comportement.
Leurs conclusions pourraient même renforcer notre compréhension de toute une série de troubles mentaux, de la dépression à la schizophrénie en passant par l'anxiété, et déboucher sur de nouveaux traitements.
Le tableau est encore loin d'être complet, mais dans le sillage de la pandémie de Covid-19, qui a eu un impact délétère sur la santé mentale des gens dans de nombreuses régions du monde, il pourrait être plus important que jamais de démêler ce puzzle.
Crédit photo, Getty Images
Des informations vérifiées à portée de main
Cliquez ici et abonnez-vous !
Fin de Promotion WhatsApp
L'une des principales histoires d'origine du domaine de la recherche s'est déroulée dans les étendues sauvages de l'Amérique du Nord - et, attention, elle donne des frissons. En 1822, un jeune commerçant du nom d'Alexis St Martin flânait à l'extérieur d'un poste de traite sur ce qui s'appelle aujourd'hui l'île Mackinac, dans l'actuel Michigan, lorsqu'un mousquet est parti accidentellement à côté de lui, lui tirant une balle dans le côté à moins de 91 cm de distance.
Ses blessures étaient si graves qu'une partie de ses poumons, une partie de son estomac et une bonne partie de son petit-déjeuner de la journée se sont écoulées par la blessure de son côté gauche. La mort semblait certaine, mais un chirurgien de l'armée nommé William Beaumont est venu à la rescousse et a sauvé la vie de St Martin, bien que cela ait pris la majeure partie d'une année et de multiples opérations chirurgicales.
Ce que Beaumont n'a pas pu réparer, cependant, c'est le trou dans l'estomac de son patient. Cette fistule persistante restera un héritage sinistre et durable de l'accident, mais Beaumont n'était pas du genre à laisser passer une bonne occasion - aussi désagréable soit-elle. Réalisant que le trou offrait une fenêtre unique sur l'intestin humain, il a passé des années à étudier les subtilités de la digestion de St Martin.
La volonté de St Martin est sujette à débat, car Beaumont l'employait comme domestique tout en menant des recherches sur lui - cet arrangement trouble ne serait certainement pas considéré comme éthique aujourd'hui. Parmi les découvertes faites par Beaumont au cours de ses études sur les entrailles de St Martin, on peut citer la façon dont elles étaient affectées par les émotions de son propriétaire, comme la colère.
Grâce à cette découverte, Beaumont, qui sera plus tard considéré comme le "père de la physiologie gastrique", a découvert l'idée d'un "axe intestin-cerveau", selon laquelle l'intestin et le cerveau ne sont pas totalement indépendants l'un de l'autre, mais interagissent, l'un influençant l'autre et vice versa. Et maintenant, nous savons que les micro-organismes présents dans notre intestin rendent ce processus encore plus complexe et remarquable.
"De plus en plus de recherches révèlent que le microbiome intestinal peut influencer le cerveau et le comportement chez une variété d'animaux différents", explique Elaine Hsiao, professeur associé en biologie intégrative et physiologie à l'université de Californie à Los Angeles (UCLA).
"Il est important de se rappeler que les microbes étaient là avant que les humains n'existent, et que nous avons donc évolué avec ces "amis avec avantages" - John Cryan
La manière dont notre microbiote pourrait influencer notre esprit est un domaine en pleine expansion, pionnier et encore relativement nouveau. Mais des progrès ont été réalisés au cours des vingt dernières années environ, notamment chez les animaux. Et, peu à peu, des arguments sont avancés pour suggérer que ces micro-organismes ne sont pas seulement une partie vitale de notre corps physique, mais aussi de notre corps mental et émotionnel.
"En médecine, nous avons tendance à compartimenter le corps", dit Cryan. "Ainsi, lorsque nous parlons de problèmes avec le cerveau, nous avons tendance à penser au cou vers le haut. Mais nous devons cadrer les choses en fonction de l'évolution. Il est important de se rappeler que les microbes étaient là avant que les humains n'existent, et que nous avons donc évolué avec ces "amis avec avantages". Il n'y a jamais eu de moment où le cerveau a existé sans les signaux provenant des microbes.
"Et si ces signaux étaient en fait très importants pour déterminer comment nous nous sentons, comment nous nous comportons et comment nous agissons ? Et si nous pouvions moduler ces microbes de manière thérapeutique pour améliorer la pensée, le comportement et la santé du cerveau ?"
Son laboratoire de l'UCLA a exploré le rôle que ces micro-organismes pourraient jouer dans tous les domaines, du développement du cerveau du fœtus à la cognition, en passant par les troubles neurologiques tels que l'épilepsie et la dépression. Elle a également étudié la manière dont ces microbes peuvent influencer notre cerveau et notre façon de penser.
"Des microbes intestinaux spécifiques peuvent moduler le système immunitaire de manière à avoir un impact sur le cerveau et produire des molécules qui envoient des signaux directs aux neurones pour réguler leur activité", explique-t-elle.
"Nous constatons que les microbes intestinaux peuvent réguler le développement précoce des neurones d'une manière qui a un impact durable sur les circuits cérébraux et les comportements. Nous constatons également qu'à plus court terme, les microbes intestinaux peuvent réguler la production de substances biochimiques, comme la sérotonine, qui stimulent activement l'activité neuronale."
En effet, la recherche suggère que nos microbes pourraient communiquer avec notre cerveau par de nombreuses voies, de l'immunité aux substances biochimiques. Un autre candidat est le nerf vague, qui agit comme une "connexion internet" ultrarapide entre notre cerveau et nos organes internes, y compris l'intestin.
La bactérie Lactobacillus rhamnosus JB1, par exemple, semble améliorer l'humeur de souris anxieuses et déprimées. Cet effet bénéfique disparaît toutefois lorsque les signaux qui circulent le long du nerf vague sont bloqués, ce qui suggère que ce dernier pourrait être utilisé comme voie de communication par les bactéries.

Crédit photo, Getty Images
La plupart des recherches dans ce domaine sont menées sur des souris (et d'autres petits animaux). Et les souris, bien sûr, ne sont pas des humains. Mais compte tenu de la complexité époustouflante de l'établissement d'un lien de causalité entre les signaux microbiens et les modifications de la pensée et du comportement humains, les études sur les animaux ont fourni des informations intéressantes sur les étranges interactions entre les bactéries et le cerveau.
Les recherches montrent, par exemple, que les rats et les souris "sans microbiote" (ceux qui n'ont pas de microbiote après avoir été élevés dans des conditions stériles) sont plus enclins à l'anxiété et moins sociables que ceux qui ont un microbiote intact.
Les souris dépourvues de microbiote et celles qui reçoivent des antibiotiques se sont également révélées plus hyperactives, sujettes à des comportements à risque et moins capables d'apprendre ou de se souvenir. Les antibiotiques, qui peuvent réduire le microbiote d'un animal, réduisent également le comportement de poussée chez le poisson zèbre, alors que les probiotiques le renforcent.
Encore une fois, le cerveau humain est beaucoup plus complexe que celui d'un rongeur ou d'un poisson, mais ils partagent certaines similitudes et peuvent donner des indices. Il est logique que les bactéries, où qu'elles vivent, aient intérêt à aider leurs hôtes à être plus sociables et moins anxieux.
En interagissant avec d'autres personnes, par exemple, nous aidons nos bactéries à se propager. Et qu'elles nous tirent ou non les ficelles, il est dans l'intérêt de l'évolution de nos microbes de rendre leur environnement aussi propice à la survie que possible.
Mais les microbes communicatifs, les poissons zèbres qui se rassemblent ou les souris amicales ont-ils vraiment de l'importance ? Si tout va bien, oui, disent les chercheurs. En fin de compte, une meilleure compréhension de ces processus pourrait nous conduire à de nouveaux traitements révolutionnaires pour toute une série de problèmes de santé mentale.
Les psychobiotiques pourraient un jour être utilisés pour nourrir les populations de "bonnes" bactéries et traiter diverses affections mentales.
"Nous avons inventé le terme "psychobiotique" pour les interventions [basées sur le microbiote] qui ont un effet bénéfique sur le cerveau humain", explique Cryan. "Et il y a de plus en plus de ces approches psychobiotiques qui arrivent".
Il y a bien sûr des mises en garde. Si certaines souches de bactéries semblent avoir un effet positif sur l'esprit humain, beaucoup d'autres ne le font pas et les chercheurs n'ont pas encore établi définitivement pourquoi - et comment. Les êtres humains sont également d'une complexité insondable, et lorsqu'il s'agit de la pensée et de la santé mentale, d'innombrables autres facteurs entrent en jeu, de la génétique à la personnalité en passant par l'environnement qui nous entoure.
"Nous avons besoin de beaucoup plus d'études à grande échelle sur l'homme pour prendre en compte ces différences individuelles", dit Cryan. "Et peut-être que tout le monde ne réagira pas de la même manière à une seule bactérie, car chacun aura de toute façon un microbiote de base légèrement différent."
Les avertissements mis à part, cependant, de nouvelles recherches pourraient apporter un nouvel espoir. "La bonne nouvelle, c'est que vous pouvez modifier votre microbiote, alors qu'il n'y a pas grand-chose que vous puissiez faire pour changer votre génétique - à part blâmer vos parents et vos grands-parents", ajoute Cryan.
"Le fait que vous puissiez modifier votre microbiote vous donne potentiellement la possibilité d'agir sur votre propre santé." En effet, les suppléments pro- et prébiotiques, de simples changements alimentaires, tels que la consommation d'aliments fermentés et de fibres - et même, peut-être, la méditation - peuvent contribuer à modifier notre microbiote de manière bénéfique pour notre esprit.
Philip Burnet, professeur associé au département de psychiatrie de l'université d'Oxford, note que de nombreux troubles mentaux ont été associés à des modifications du microbiote. Souvent, ce déséquilibre ou "dysbiose" se caractérise par une quantité réduite de certaines bactéries, notamment celles qui produisent des acides gras à chaîne courte (comme le butyrate, dont on pense généralement qu'il améliore la fonction cérébrale) lorsqu'elles décomposent les fibres dans l'intestin.
En effet, une étude menée en 2019 par Mireia Valles-Colomer, microbiologiste à l'Université KU Leuven en Belgique à l'époque, et ses collègues ont trouvé une corrélation entre la quantité de ces bactéries productrices de butyrate et le bien-être.
Plus précisément, les chercheurs ont noté dans l'étude que : "Les bactéries Faecalibacterium et Coprococcus productrices de butyrate étaient systématiquement associées à des indicateurs de qualité de vie plus élevés. Avec Dialister, les Coprococcus spp. étaient également appauvries en cas de dépression, même après correction des effets confondants des antidépresseurs."

Crédit photo, Getty Images
Les études humaines sur la communication entre l'intestin, le cerveau et le microbiote sont encore relativement rares. Et Burnet appelle à la prudence : "On ne sait pas si ces niveaux altérés de bactéries intestinales sont à l'origine de la mauvaise humeur ou si les nombres microbiens changent parce que les personnes déprimées peuvent modifier leurs habitudes alimentaires ou manger moins."
Néanmoins, il a exploré comment les prébiotiques (qui encouragent les bactéries à se développer) et les probiotiques (bactéries vivantes) pourraient un jour être utilisés comme psychobiotiques pour nourrir les populations de "bonnes" bactéries - et traiter une variété de conditions de santé mentale.
Par exemple, une étude menée en 2019 par Burnet, Rita Baião, une psychologue également de l'université d'Oxford, et leurs collègues a permis de découvrir des résultats particulièrement intéressants.
Bien que l'étude ait été financée par une entreprise qui fabrique des bactéries probiotiques, elle a utilisé un essai randomisé, en double aveugle et contrôlé par placebo - considéré comme un modèle d'étude de référence au cours duquel ni les participants ni les chercheurs ne savent s'ils reçoivent le traitement ou non.
Les chercheurs ont étudié l'effet qu'un probiotique multi-espèces pourrait avoir sur le traitement des émotions et la cognition chez des personnes souffrant de dépression légère à modérée. Mais ils ont également surveillé leur humeur avant et après l'expérience à l'aide du Patient Health Questionnaire-9 (PHQ-9), qui mesure la gravité de la dépression.
Les participants, qui ne prenaient aucun autre médicament, ont reçu soit un placebo, soit un probiotique disponible dans le commerce - qui contient 14 espèces de bactéries, dont Bacillus subtilis, Bifidobacterium bifidum, Bifidobacterium breve et Bifidobacterium infantis - pendant quatre semaines.
Les résultats ont été fascinants, notamment le fait que les participants ayant pris le probiotique ont connu une amélioration subjective significative de leur humeur par rapport au groupe sous placebo, devenant essentiellement moins déprimés selon le PHQ-9. Les changements dans les niveaux d'anxiété des participants, qui ont également été mesurés, n'ont pas été observés.
Il s'agit d'une étude brève et de petite taille (71 participants) et des recherches supplémentaires sont nécessaires pour prouver la causalité. Mais c'est une première indication que les "psychobiotiques" pourraient un jour être un traitement utile pour les personnes souffrant de dépression - en particulier celles qui sont réticentes à consulter un médecin ou à prendre des antidépresseurs traditionnels, dit Burnet. En effet, les psychobiotiques ne remplaceront pas les médicaments existants, mais pourraient éventuellement constituer un complément utile.
"Ils ne rendront pas tout le monde plus heureux", dit Burnet, mais les probiotiques pourraient un jour compléter les traitements de santé mentale plus établis. "Seul le temps nous dira si nous aurons des psychobiotiques", ajoute-t-il. "Mais le domaine est vraiment en train de progresser [...] Ce domaine de recherche est toutefois dominé par les études sur les animaux, nous avons donc besoin de plus d'études sur les humains avec un plus grand nombre de participants."
Mais le potentiel des psychobiotiques a frappé les imaginations.
Les personnes qui avaient pris des antibiotiques pendant de longues périodes ont obtenu des résultats inférieurs aux tests cognitifs tels que l'apprentissage, la mémoire de travail et les tâches d'attention.
"Nous avons également suscité un grand intérêt de la part du public", ajoute M. Burnet. "Les gens sont extrêmement intéressés par le maintien de leur santé et de leur bien-être à l'aide de suppléments naturels et le fait d'encourager la croissance de bonnes bactéries pour soutenir la santé mentale a capté l'imagination du grand public. Surtout maintenant, alors que les gens sont plus anxieux et déprimés à cause de la pandémie."
En collaboration avec Amy Chia-Ching Kao et d'autres chercheurs, M. Burnet a également exploré le rôle que ces micro-organismes pourraient jouer dans la psychose, et s'est demandé si les prébiotiques (qui favorisent la croissance des bactéries dans l'intestin) pouvaient aider les personnes atteintes de cette maladie à avoir les idées plus claires.
Beaucoup de gens savent que la psychose peut provoquer des hallucinations, des délires et un détachement de la réalité. Mais les personnes atteintes de psychose rencontrent aussi souvent des difficultés dans les fonctions cognitives telles que l'attention, la mémoire et la résolution de problèmes, ce qui peut avoir un impact sur leur capacité à conserver un emploi et à nouer des relations. Si les médicaments peuvent être utilisés pour traiter les hallucinations et les délires, il est plus difficile d'améliorer les déficiences cognitives des personnes atteintes.
Une étude croisée en double aveugle, contrôlée par placebo, menée par Burnet et Chia-Ching Kao, suggère toutefois une voie possible. "Nous avons constaté que l'administration d'un prébiotique à des personnes atteintes de psychose améliorait effectivement la fonction cognitive selon les échelles cliniques", explique Burnet.
Au début de l'étude, les participants étaient sous traitement et ne présentaient pas de symptômes psychotiques, mais souffraient toujours des troubles cognitifs typiques de la psychose. Pendant 12 semaines, ils ont reçu un prébiotique ou un placebo, tandis que leur métabolisme, leur immunité et leur niveau de déficience cognitive étaient mesurés au fil du temps. À la fin des 12 semaines, ils ont été échangés, de sorte que les deux groupes ont reçu le même nombre d'heures de prébiotique et de placebo.
Et l'effet était faible mais significatif. Le prébiotique a amélioré la fonction cognitive globale, en particulier l'attention et la résolution de problèmes, ce qui a amené les chercheurs à conclure que cette amélioration était suffisante pour stimuler le bien-être social et mental. Rien n'indique que l'immunité ou le métabolisme des participants ait changé, de sorte qu'on ne sait pas comment le prébiotique a pu déclencher cet effet. Mais il s'agit d'un autre petit pas vers la compréhension de la relation entre notre microbiote et notre santé mentale et le développement potentiel de nouveaux traitements pour les troubles qui affectent notre pensée.
Certains indices laissent penser que le microbiote intestinal peut également affecter les capacités cognitives de manière plus générale. Il est bien connu que les antibiotiques perturbent le microbiote intestinal, mais ont-ils un impact sur notre cognition ?
Une étude récente, qui a suivi la santé et le bien-être de 14 542 infirmières pendant plusieurs années alors qu'elles travaillaient pour le NHS au Royaume-Uni, a révélé que celles qui avaient pris des antibiotiques pendant de longues périodes (plus de deux mois) obtenaient de moins bons résultats aux tests cognitifs tels que les tâches d'apprentissage, de mémoire de travail et d'attention que celles qui n'avaient pas pris de tels médicaments.
Fait important, la cognition des femmes qui avaient pris des antibiotiques était légèrement moins bonne lorsqu'elles ont été suivies sept ans plus tard. Bien qu'il ne s'agisse que d'une corrélation, les chercheurs pensent que cela pourrait être dû aux changements induits par les antibiotiques dans l'intestin.

Crédit photo, Getty Images
Mais il reste encore beaucoup de chemin à parcourir pour bien comprendre ce phénomène. Il s'agit d'un domaine fascinant mais très complexe, et la recherche nécessite des fonds. Les récompenses, cependant, pourraient être profondes. "Il n'y a qu'une poignée de microbes spécifiques qui ont été étudiés jusqu'à présent", explique Hsiao.
"Pas nécessairement parce qu'ils sont les plus importants, mais parce que nous, en tant que scientifiques, avons encore beaucoup à faire pour vraiment comprendre l'énorme diversité des microbes dans l'intestin et la façon dont ils fonctionnent individuellement et en communauté".
"Je suis très enthousiaste à l'idée de découvrir de nouveaux mécanismes permettant de comprendre comment nous et nos symbiotes microbiens pouvons travailler ensemble pour promouvoir la santé et contrecarrer les maladies."
En attendant, nous devrions peut-être tous accorder un peu plus d'attention à notre microbiote. Un régime méditerranéen riche en fibres, en particulier dans les légumes, est probablement un bon point de départ. Les aliments fermentés, tels que le kimchi et le kéfir (une boisson lactée fermentée), peuvent également être bénéfiques.
Dans une petite étude menée auprès de 45 participants, par exemple, Cryan et ses collègues ont montré que les personnes soumises à un régime alimentaire comprenant beaucoup de fibres, de prébiotiques et d'aliments fermentés (comme les oignons, le yaourt, le kéfir et la choucroute), ont déclaré se sentir moins stressées qu'un groupe témoin soumis à un régime différent.
"Ce que j'aime dans les aliments fermentés, c'est qu'ils démocratisent la science", dit Cryan. "Ils ne coûtent pas vraiment cher et vous n'avez pas besoin de vous les procurer dans un magasin chic. Vous pouvez le faire vous-même. Dans ce domaine, nous voulons offrir des solutions de santé mentale aux personnes de tous les milieux socio-économiques."
La relation que nous entretenons avec notre microbiote est "un peu comme une fédération", ajoute Cryan. "Ces microbes sont nos compagnons de route". Nous ferions bien de nous en souvenir - pour le bien de notre santé physique et, très probablement, mentale.
* Avez-vous les idées claires ? 29 Reasons You Aren't, And What To Do About It de Miriam Frankel et Matt Warren est publié par Hodder Studio.
























